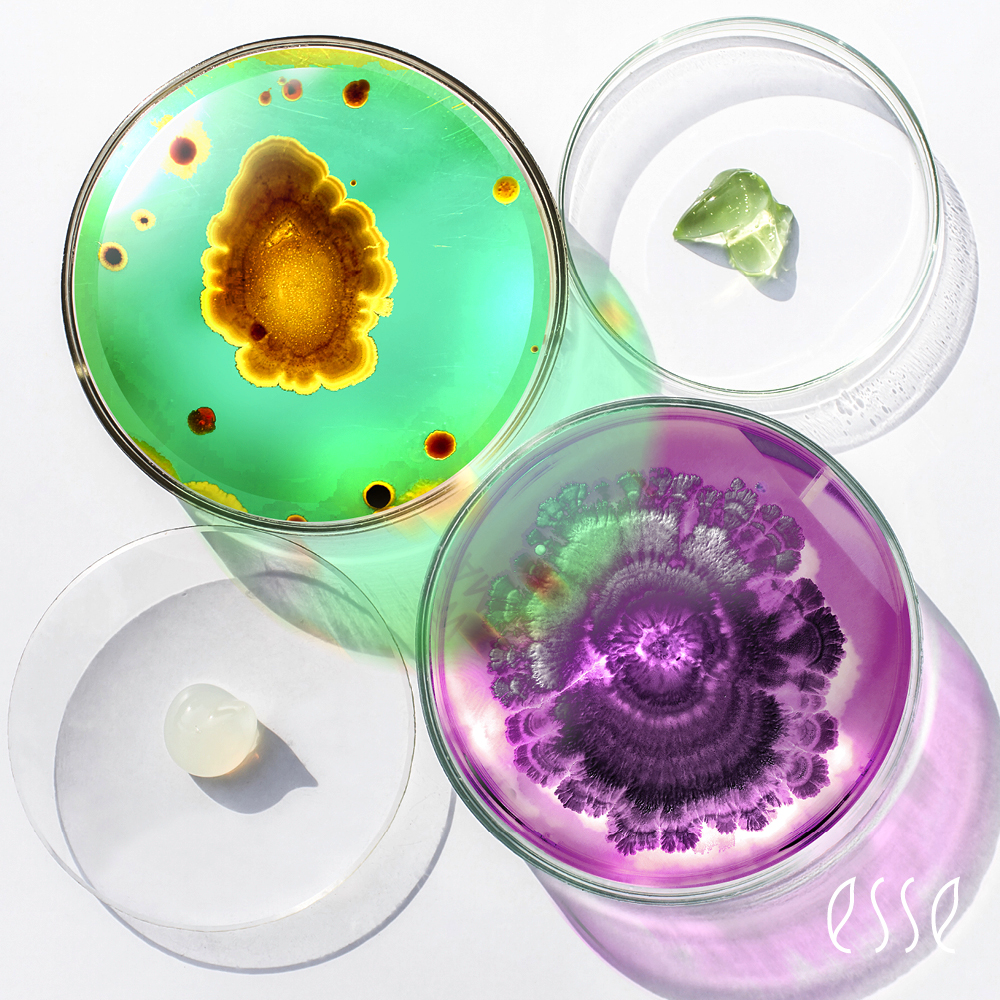
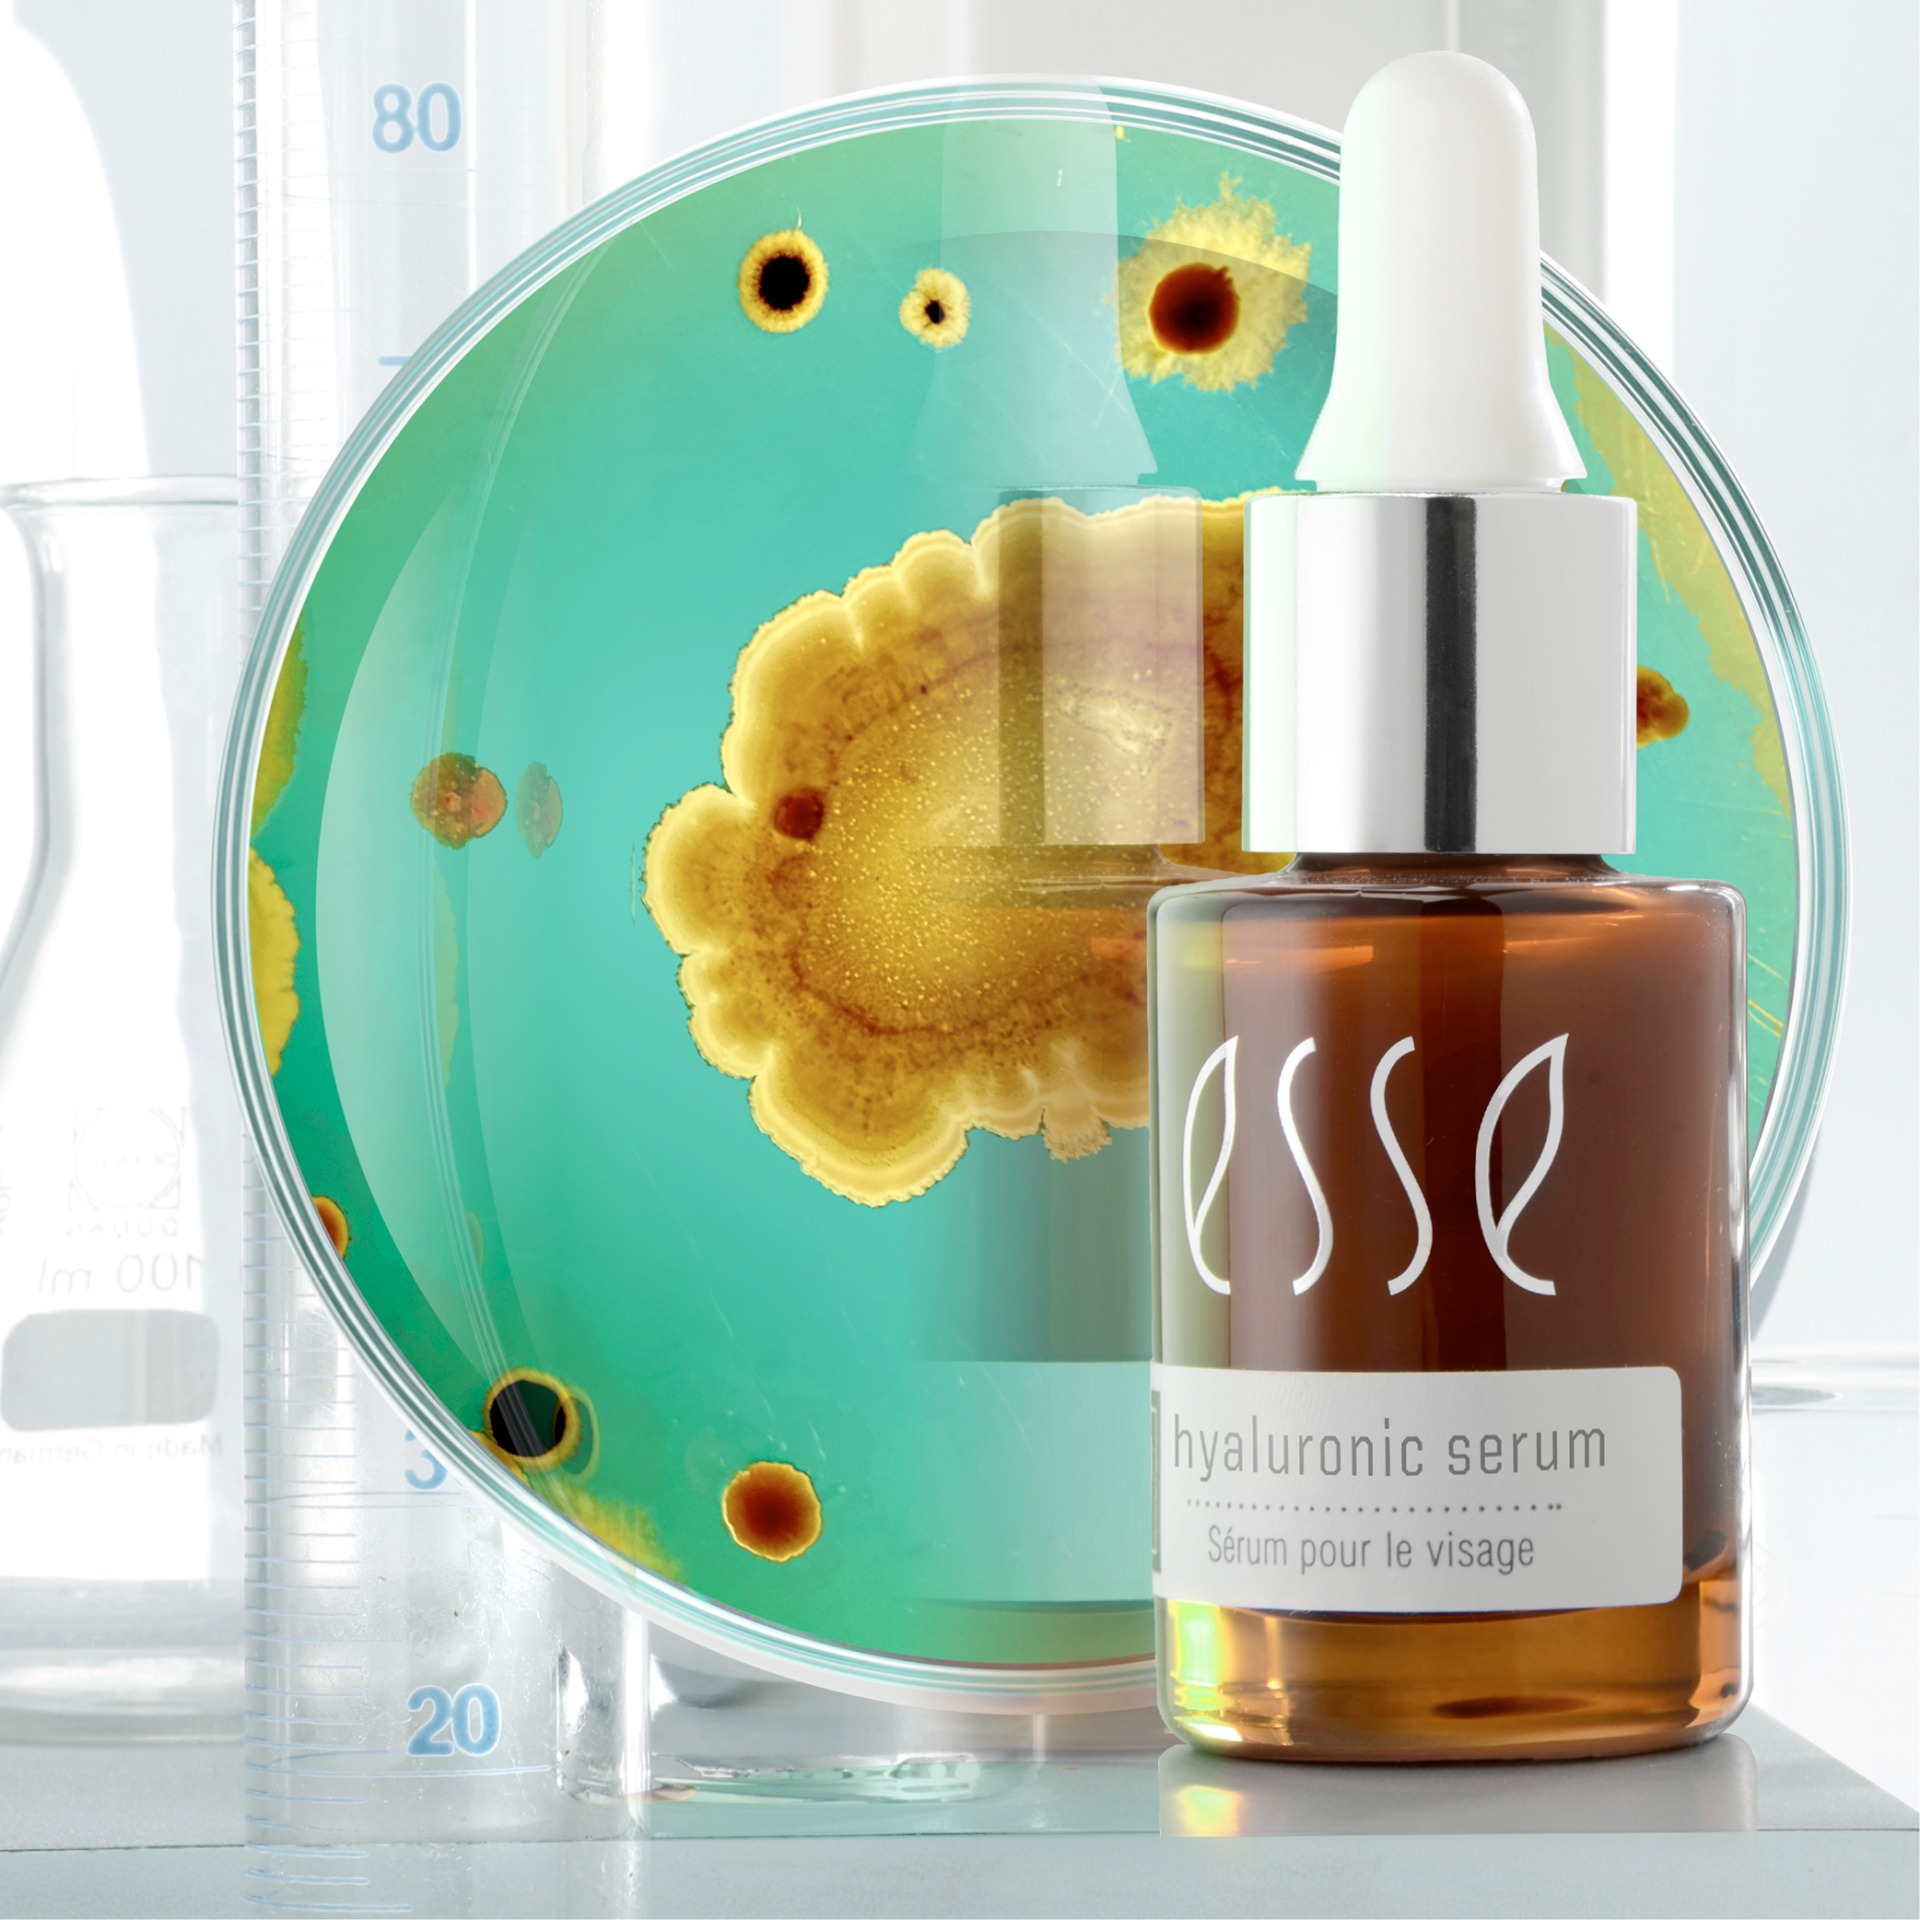

Mikrobiom pleti
Mikrobiom pleti: klíč k zdravé, vyrovnané a odolné pokožce
Mikrobiom pleti patří mezi nejdůležitější témata moderní kosmetologie a dermatologie. Vědecké studie potvrzují, že stav kožního mikrobiomu zásadně ovlivňuje zdraví pokožky, její citlivost, sklon k akné, zánětům i předčasnému stárnutí.
Mikrobiom pleti patří mezi nejdůležitější témata moderní kosmetologie a dermatologie. Vědecké studie potvrzují, že stav kožního mikrobiomu zásadně ovlivňuje zdraví pokožky, její citlivost, sklon k akné, zánětům i předčasnému stárnutí.
Zdravá pleť není sterilní. Naopak – je výsledkem rovnováhy mezi pokožkou a mikroorganismy, které na ní přirozeně žijí.
Co je mikrobiom pleti?
Mikrobiom pleti je soubor mikroorganismů (bakterií, kvasinek a dalších mikrobů) a jejich genetické informace, které osídlují povrch kůže. Tyto mikroorganismy tvoří přirozenou součást kožní bariéry a podílejí se na jejím správném fungovaní.
Každý člověk má unikátní kožní mikrobiom, který je ovlivněn:
- genetikou
- hormonálními změnami
- věkem
- stresem
- životním stylem
- používanou kosmetikou
Proč je mikrobiom pleti důležitý?
Mikrobiom hraje klíčovou roli v ochraně pokožky před vnějšími vlivy. Funguje jako biologický ochranný štít, který spolupracuje s imunitním systémem kůže.
Zdravý mikrobiom pleti:
-
chrání před patogenními bakteriemi
-
podporuje přirozené pH pokožky
-
posiluje kožní bariéru
-
reguluje zánětlivé reakce
-
podporuje regeneraci pleti
Narušení mikrobiomu (tzv. dysbióza) je spojováno s výskytem akné, rosacey, atopického ekzému i zvýšené citlivosti pleti.
Jak mikrobiom ovlivňuje stav pleti?
Vyvážený mikrobiom pomáhá pokožce:
-
udržovat optimální hydrataci
-
lépe se bránit vnějším vlivům
-
zůstat klidná a méně reaktivní
-
zpomalovat proces stárnutí
Naopak poškozený mikrobiom se často projevuje:
-
pnutím a suchostí
-
zarudnutím
-
častými záněty
-
nadměrnou mastnotou nebo akné
Mnoho kožních problémů tak nevzniká "špatnou pletí", ale nesprávnou kosmetickou péčí, která mikrobiom dlouhodobě narušuje.
Proč je důležité mikrobiom pleti chránit?
Tradiční kosmetická péče byla dlouhodobě založena na odstraňování bakterií a "dokonalé čistotě". Moderní výzkum však ukazuje, že přehnané čištění pleti je jedním z hlavních faktorů poškození mikrobiomu.
Nevhodná kosmetika může:
-
ničit prospěšné mikroorganismy
-
narušovat přirozené pH pokožky
-
oslabovat kožní bariéru
-
zvyšovat citlivost a reaktivitu pleti
Dlouhodobým cílem péče o pleť by proto neměla být sterilita, ale stabilita a rovnováha.
Probiotická kosmetika a mikrobiom pleti
Probiotická a prebiotická kosmetika představuje moderní přístup k péči o pleť. Jejím cílem není mikroorganismy ničit, ale podporovat růst těch prospěšných a vytvářet optimální podmínky pro zdravý mikrobiom.
Jednou ze značek, která tento přístup dlouhodobě rozvíjí, je ESSEskincare.
Proč je kosmetika ESSEskincare vhodná pro mikrobiom pleti?
Kosmetika ESSEskincare je vyvíjena na základě vědeckých poznatků o kožním mikrobiomu a jeho vlivu na zdraví pleti.
Produkty ESSE skincare:
-
respektují přirozené pH pokožky
-
obsahují prebiotické a probiotické složky
-
podporují obnovu kožní bariéry
-
neobsahují agresivní konzervanty ani syntetickou parfemaci
-
jsou zaměřené na dlouhodobé zdraví pleti, ne jen na rychlý efekt
Cílem této péče je obnovit přirozenou rovnováhu pokožky a posílit její vlastní obranné mechanismy.
Proč běžná drogérijní kosmetika mikrobiomu často škodí?
Většina běžné kosmetiky je formulována s důrazem na:
-
dlouhou trvanlivost
-
univerzální použití
-
okamžitý vizuální efekt
To často znamená použití silných detergentů, parfemací, alkoholu a konzervantů, které mohou mikrobiom pleti dlouhodobě narušovat.
Krátkodobě může pleť působit hladší nebo "čistší", ale z dlouhodobého hlediska se stává citlivější, reaktivnější a závislou na produktech.
Závěr: zdravá pleť začíná u mikrobiomu
Mikrobiom pleti není trend, ale vědecky podložený základ zdravé pokožky. Správná kosmetická péče by měla mikrobiom chránit, podporovat a respektovat – nikoli ho ničit.
Pokud chceme dlouhodobě zdravou, odolnou a vyrovnanou pleť, je práce s mikrobiomem klíčovým krokem moderní kosmetické péče.
Doporučené odborné zdroje:
-
The Skin Microbiome – National Institutes of Health (PMC)
-
Skin Microbiome in Health and Disease – Clinical, Cosmetic and Investigational Dermatology
-
Cutaneous Microbiome in Dermatology – přehledová vědecká studie

K vizuálnímu členění textu slouží obrázkové sekce
Kromě nadpisů vám s členěním textu na správných místech pomohou i obrázkové sekce. Jednotlivé odstavce vašeho článku oddělte obrázky, které vhodně doplní obsah.
Pokud uvádíte důležitá slova či myšlenky, použijte pro zvýraznění textu citaci.
Váš text začíná právě zde. Klikněte a můžete začít psát. Sed ut perspiciatis unde omnis iste natus error sit voluptatem accusantium doloremque laudantium totam rem aperiam eaque ipsa quae ab illo inventore veritatis et.
